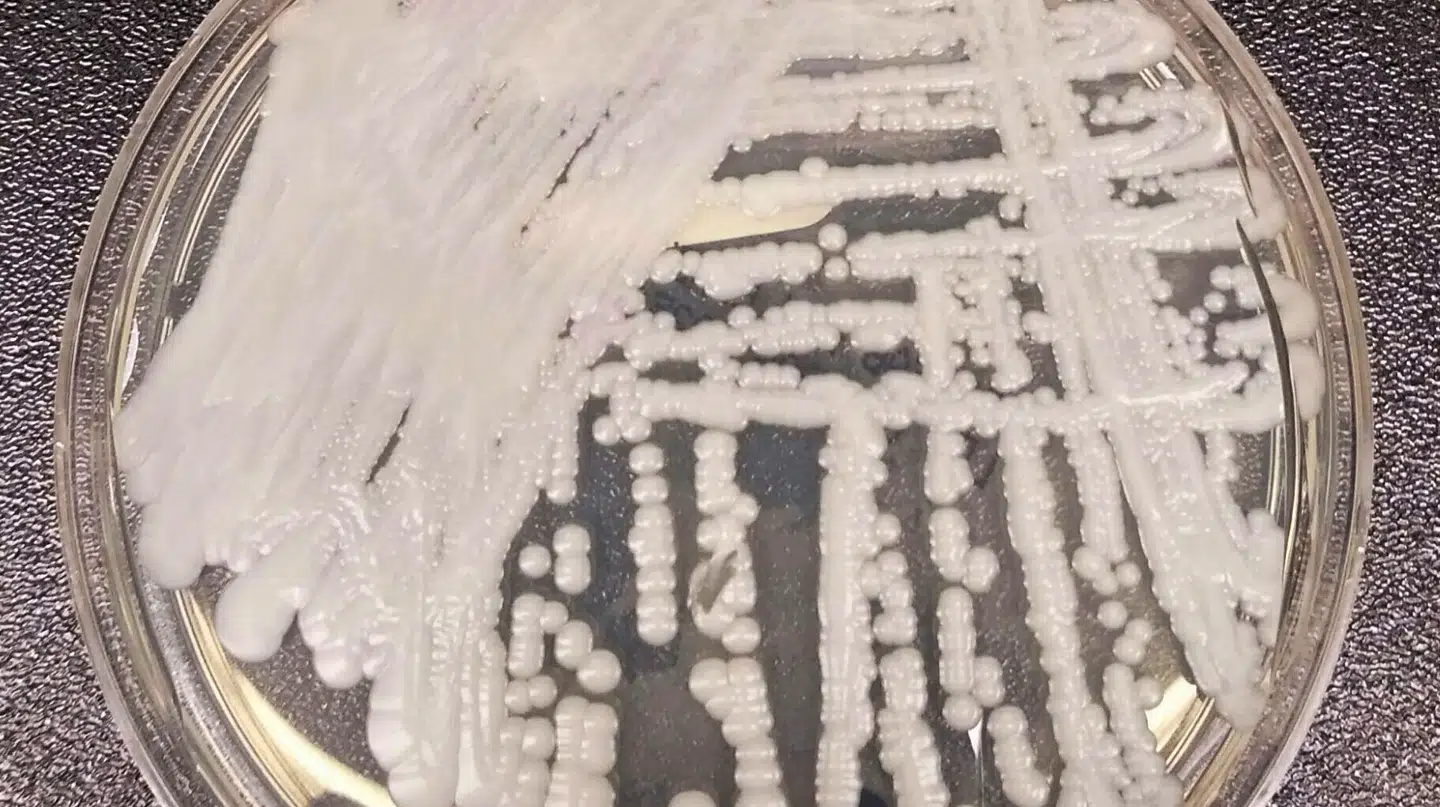
C. auris er en gærsvamp, der kan være dødelig for svækkede patienter. Den er resistent over for mange typer antibiotika og udgør derfor en risiko på hospitaler og plejehjem. På billedet ses en stamme af svampen dyrket i et laboratorium.

En dødelig gærsvamp spreder sig på hospitaler i Europa – og den kan være livsfarlig.
Så klart lyder advarslen efter Det Europæiske Center for Sygdomsforebyggelse og -kontrol (ECDC) er udkommet med en ny rapport.
Her peges der på svampen Candida auris, ofte kaldet C. auris, som er resistent over for mange former for svampedræbende medicin og derfor meget svær at behandle, skriver TV 2 Norge.
Hos personer med svækket immunforsvar kan den forårsage alvorlige infektioner i blod, hjerne, rygmarv, knogler, ører, urinveje og luftveje.
En undersøgelse fra CDC, USA’s nationale sundhedsmyndighed, anslår, at hver tredje patient, der rammes af infektionen, dør.
»Patienter med nedsat immunforsvar er særligt udsatte, og der har været en stigende bekymring knyttet til resistens for netop denne art,« siger Espen Rostrup Nakstad, der står i spidsen for Norges nationale behandlingstjeneste for CBRNE-medicin ved Oslo Universitetshospital, til mediet.
Han leder den medicinske enhed, der håndterer nødsituationer, hvor patienter rammes af kemiske, biologiske, radiologiske, nukleare eller eksplosive trusler.
Raske mennesker kan godt være bærere af C. auris uden at få symptomer, men for kritisk syge patienter er svampen altså yderst farlig.
Det første udbrud blev registreret i Valencia i Spanien i 2016. Siden 2013 er der registreret 4012 tilfælde i Europa – og alene i 2023 blev en tredjedel af dem bekræftet. Ifølge ECDC frygtes der desuden store mørketal.